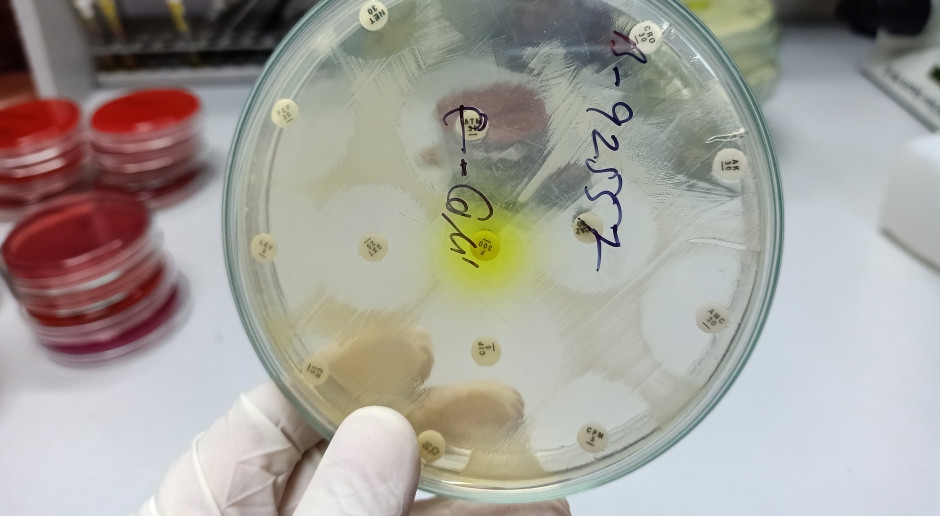
"Wyprzedza postępy medycyny". Zagrożenie rośnie, nowy alarm ogłoszony

"Wyprzedza postępy medycyny". Zagrożenie rośnie, nowy alarm ogłoszony

Autor: Alina Gałka • Źródło: Rynek Zdrowia • Opublikowano: 07 listopada 2025 20:43
Globalny wzrost oporności na antybiotyki przyspiesza i według ekspertów Światowej Organizacji Zdrowia (WHO) stanowi poważne zagrożenie. Obecnie jedna na sześć infekcji o potwierdzonym podłożu bakteryjnym wywołana jest przez patogen oporny na antybiotyki.
- WHO alarmuje, że jedna na sześć infekcji bakteryjnych jest obecnie wywołana przez patogen oporny na antybiotyki
- W latach 2018-2023 oporność wzrosła w ponad 40 proc. badanych przypadków, średnio o 5-15 proc. rocznie
- Najwyższy poziom oporności odnotowano w Azji Południowo-Wschodniej, regionie śródziemnomorskim i Afryce, gdzie nawet 70 proc. zakażeń jest opornych na leczenie
- Bakterie Gram-ujemne, zwłaszcza E. coli i K. pneumoniae, stanowią największe zagrożenie - często prowadzą do sepsy i zgonu
- WHO ostrzega, że oporność na leki ratujące życie rośnie szybciej niż postęp medycyny, szczególnie w krajach o słabych systemach ochrony zdrowia
Jak wynika analiz WHO, w latach 2018-2023 oporność na antybiotyki wzrosła w ponad 40 proc. monitorowanych kombinacjach patogen-antybiotyk, przy średnim rocznym wzroście na poziomie 5-15 proc. Z danych pochodzących z ponad 100 państw wynika, że rosnąca oporność na podstawowe antybiotyki stanowi coraz poważniejsze zagrożenie dla zdrowia publicznego na świecie.
Zagrożenie nie rozkłada się równomiernie- Oporność na środki przeciwdrobnoustrojowe wyprzedza postępy nowoczesnej medycyny, zagrażając zdrowiu rodzin na całym świecie - powiedział dr Tedros Adhanom Ghebreyesus, dyrektor generalny WHO.
Największy poziom oporności na antybiotyki występuje w rejonach Azji Południowo-Wschodniej oraz w części basenu Morza Śródziemnego; w regionie afrykańskim dotyczy jednego na pięć zakażeń. Oporność częściej występuje i szybciej się nasila w krajach, gdzie systemy opieki zdrowotnej mają ograniczoną zdolność do diagnozowania lub leczenia zakażeń bakteryjnych.
Z najnowszego raportu "Global antibiotic resistance surveillance report 2025" [1] wynika, że największe zagrożenie stwarzają bakterie Gram-ujemne, takie jak E. coli i K. pneumoniae. Takie zakażenia często prowadzą do rozwoju sepsy, niewydolności narządów i zgonu. Obecnie aż 40 proc. szczepów E. coli i ponad 55 proc. K. pneumoniae na świecie jest opornych na podstawowe leki stosowane w przebiegu takich infekcji; w regionie afrykańskim oporność przekracza nawet 70 proc.
– Główne ustalenia raportu budzą niepokój. Oporność na leki ratujące życie jest bardzo wysoka i nadal rośnie, szczególnie w krajach o ograniczonych zasobach - zauważa we wstępie do dokumentu dr Yukiko Nakatani.
Materiał chroniony prawem autorskim - zasady przedruków określa regulamin.
rynekzdrowia